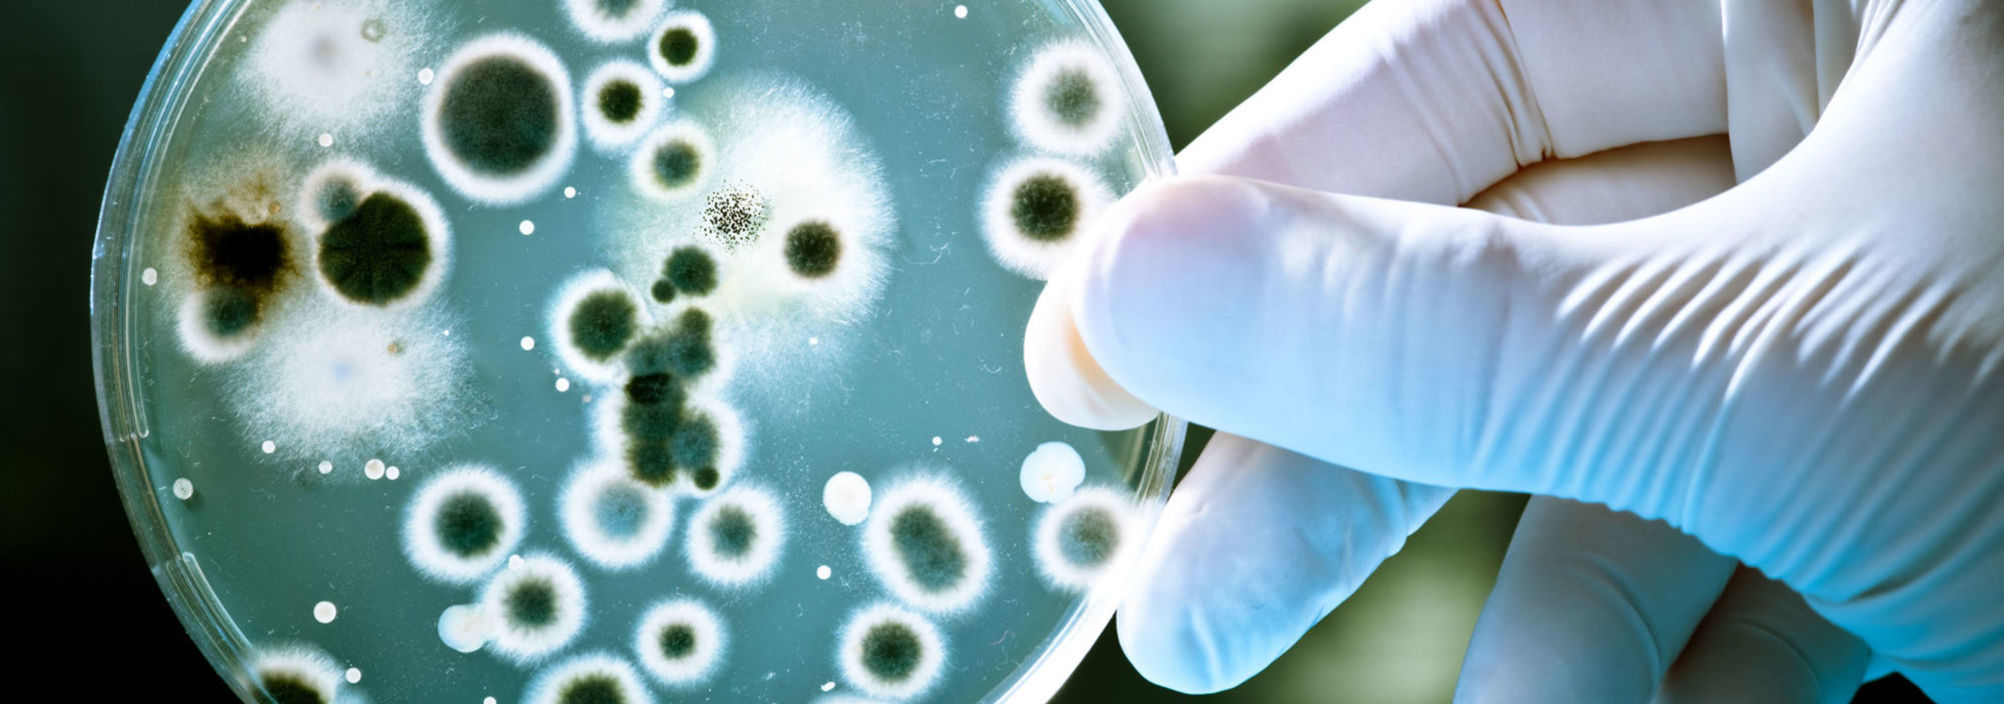
Harrington Discovery Institute Accelerates Breakthrough Science into Cancer Treatments and Cures. Harrington Advances Science to Medicine through Philanthropy. The image portrays a petri dish held by a gloved hand.

Support Cures Today
Harrington Discovery Institute brings hope through results and engages families in the shared mission to find cures. Discover your impact.
Medicines in the making
Companies launched
Medicines in the clinic
Licenses to pharma
Welcome to Harrington Discovery Institute, a leading force in the pursuit of innovative solutions to conquer treatments and a cure for Alzheimer's disease. If you're a passionate donor seeking to make a significant impact in the fight against this formidable disease, you've come to the right place.
What sets Harrington apart is our ability to provide more than just financial support. We go beyond traditional philanthropy by offering expert guidance and leveraging strategic partnerships with former pharma business leaders. This collaborative approach empowers scientists and researchers to accelerate the development and commercialization of potential treatments.

There are 55 million people worldwide living with Alzheimer's or other dementias. With 500,000 new cases of Alzheimer's disease estimated to be diagnosed this year in the US, the need for treatments has never been more urgent.
The Harrington Brain Health Medicines Center provides funding and drug development support to researchers whose work aims to treat or prevent Alzheimer’s disease (AD) and related dementias.
For decades, AD research has focused predominantly on ways to reduce beta amyloid plaques and tau tangles in the brain, which were the defining features of AD when it was discovered over a century ago. But these efforts have had very limited success. There are other promising pathways for therapy in AD, however, such as the various efforts being implemented by Harrington supported scholars.

At Harrington Discovery Institute, we believe in the power of collective action to drive meaningful change. Join us in our mission to cure devastating diseases and transform lives. By signing up for our emails, you'll stay connected with the latest breakthroughs, success stories, and opportunities to make a difference.
Stay informed, inspired, and empowered to take action. Together, we can create a world where devastating diseases are conquered, and lives are forever changed.
Our resources are your gateway to staying informed and connected with the latest breakthroughs and updates from Harrington Discovery Institute. Delve into our collection of insightful blogs, news articles, and updates that showcase our groundbreaking research initiatives and the impact we're making.
Explore our blogs, news articles, and thought-provoking content that shed light on the path to a future free from devastating diseases. From cutting-edge discoveries to personal journeys of triumph, click below to find inspiration and information.